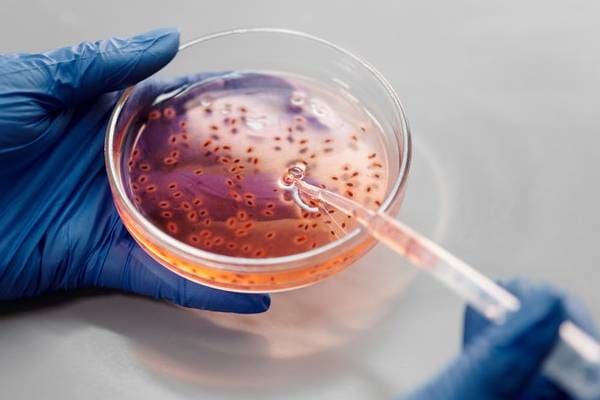

நீரிழிவு நோய்க்கான புதிய சிகிச்சை கண்டுபிடிப்பு
நீரிழிவு நோயை செல் சிகிச்சை மூலம் குணப்படுத்தும் புதிய முறையை சீனாவில் (China) உள்ள ஒரு ஆராய்ச்சி குழு கண்டுபிடித்துள்ளதாக தெரிவிக்கப்பட்டுள்ளது.
ஷாங்காய் – சாங்ஷெங் மற்றும் ரென்ஜி மருத்துவமனைகளைச் சேர்ந்த மருத்துவர்கள் குழு இந்த மேம்படுத்தப்பட்ட செல் அமைப்பைக் கண்டுபிடித்ததாக வெளிநாட்டு ஊடகங்கள் செய்தி வெளியிட்டுள்ளன.
சவுத் சைனா மார்னிங் போஸ்ட்டின் அறிக்கையின்படி, தேர்ந்தெடுக்கப்பட்ட நீரிழிவு நோயாளிக்கு ஜூலை 2021 இல் செல் மாற்று அறுவை சிகிச்சை செய்யப்பட்டுள்ளது.
அதன்படி, அவர் 2022 ஆம் ஆண்டிலிருந்து படிப்படியாக தனது நீரிழிவு மருந்தை விட்டுவிட்டு, தற்போது இன்சுலின் இல்லாமல் வாழ்ந்து வருவதாக தெரியவந்துள்ளது.
இந்த நிலையில், பிரிட்டிஷ் கொலம்பியா பல்கலைக்கழகத்தின் பேராசிரியரான திமோதி கீஃபர், இந்த ஆய்வு நீரிழிவு சிகிச்சையில் குறிப்பிடத்தக்க முன்னேற்றம் என்று பாராட்டியுள்ளமை குறிப்பிடத்தக்கது.